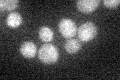
YDR072C
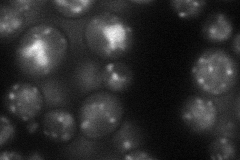
YDR072C
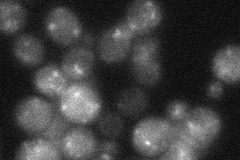
YDR072C
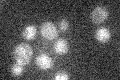
YDR072C

View description
Inositolphosphotransferase, involved in synthesis of mannose-(inositol-P)2-ceramide (M(IP)2C), the most abundant sphingolipid;, can mutate to resistance to the antifungals syringomycin E and DmAMP1 and to K. lactis zymocin
Localization:
Intensity:
Fold change:
Significance:
-
C’ GFP library in SD
cytosol21.12 -
N' NOP1pr-GFP in SD
punctate34.8646 -
N' TEF2pr-mCherry in SD

vacuole58.6685 -
N' NATIVEpr-GFP in SD
punctate30.9119 -
N' TEF2pr-VC and Cyto-VN in SD

below threshold24.5168 -
C’ GFP library in SD+DTT

cytosol20.750.98No -
C’ GFP library in SD+H2O2

cytosol18.290.86No -
C’ GFP library in Starvation Media
cytosol15.850.75No -
C’ GFP library on the background of Pup2-DaMP

cytosol -
C’ GFP library on the background of CCT mutant

cytosol16.43650.778008No
